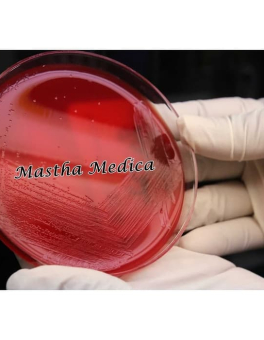

● online
- Slot Yang Banyak Menang....
- Justspin Casino 50 Free Spins....
- Situs Blackjack Kasino Tanpa Setoran 2025....
- Situs Kasino Dengan Gratis Tanpa Setoran....
- Situs Rolet Online Winrate Tertinggi....
- Perbandingan Terbaik Kasino Online 2025....
- Craps Casino Id 2025 Review....
- Mesin Spin Untuk Kasino 2025....
IK Sparepart Tensimeter Balon Pompa Tensi Riester Hitam Anda punya Tensimeter ? Tapi sparepart pompa Tensi Anda Rusak ? Atau Balon Pompa tensi Anda bocor ? Kami menjual sparepart Balon pompa tensi yang Anda inginkan dengan harga yang murah dan kualitas terbaik. Bola tensi digunakan saat memompa untuk mengukur tekanan darah seseorang terhadap detak… selengkapnya
Rp 410.000 Rp 475.000Ik Kursi Roda Travel Traveling Umroh Haji Kecil+Tas KY900LB M.Green Sella Mencari Kursi Roda Travelling Kecil yang bisa masuk Mobil Kecil / City Car? Kami sarankan untuk menggunakan kursi roda travelling Sella KY900lb dengan motif baru M. green Selain mudah dilipat menjadi kecil, Kursi Roda Kecil ini gagang atasnya bisa dilipat kebawah sehingga mudah… selengkapnya
Rp 1.250.000 Rp 1.980.000Ik Tabung Vaculab Plain 3ml Blood Collection Penampung Sampel Darah Vaculab plain 3ml ini banyak digunakan untuk pemeriksaan Hematologi. Vacum memberikan perlindungan komprehensif terhadap sel darah agar proses koagulasi dapat dipecah serta menjaga bentuk dan volume sel darah tetap terlindungi dalam waktu yang lama. Spesifikasi : – Tabung Vaculab Plain – Ukuran 3 ml –… selengkapnya
Rp 150.000 Rp 215.000Ik Manekin Torso Bayi Alat Peraga Baby Plastik Anda butuh torso bayi ? Atau untuk praktik perwatan bayi ? Kami menjual Torso Bayi yang Anda mau dengan harga yang Murah, dan berkualitas Manekin bayi digunakan untuk praktik perwatan bayi atau untuk pelatigan kebidanan. Manekin ini terbuat dari plastik. Spesifikasi : – Nama : Manekin… selengkapnya
Rp 710.000 Rp 950.000Ik Kaca mulut, yaitu sebuah kaca kecil berbentuk bundar dan diberi gagang. Alat ini akan dimasukkan ke dalam rongga mulut untuk melihat keadaan gigi dan jaringan di sekitar gigi. Kaca mulut merupakan peralatan utama. Dengan alat ini, lubang yang tersembunyi dapat dilihat oleh dokter gigi. Tangkai terbuat dari logam dan Kaca bulat. Kegunaan : –… selengkapnya
*Harga MulaiRp 50.000
NB : UNTUK PENGIRIMAN WAJIB MENGGUNAKAN EKSPEDISI JNE YES IK Media Plate Alat Laboratorium MRSA Chromogenic Agar 1 Pack 10 pcs MRSA Chromogenic Agar adalah cawan atau wadah berbentuk bundar yang memiliki tutup terbuat plastik dan menjadi kelengkapan laboratorium. Alat ini berfungsi untuk media cair dan padat (agar) siap pakai mencakup semua bidang dalam… selengkapnya
Rp 1.155.000 Rp 1.205.000NB : UNTUK PENGIRIMAN WAJIB MENGGUNAKAN JNE YES ik Darah Domba / Blood Agar Base Kualitas Terbaik Darah Domba adalah bahan yang sangat diperlukan dalam pembuatan berbagaimedia hidup di Laboratorium Mikrobiologi, diantaranya : – Agar Darah – Blood Agar Base – Agar Coklat – Agar Mac Conkey – Agar Darah Telurit, – Sabouraud Maltose/Dextrose… selengkapnya
Rp 1.930.000 Rp 2.250.000NB : UNTUK PENGIRIMAN WAJIB MENGGUNAKAN EKSPEDISI JNE YES IK Macconcay Agar Prepared Plate Media Alat Laboratorium 1 Pack 10 pcs Macconcay Agar adalah cawan atau wadah berbentuk bundar yang memiliki tutup terbuat plastik dan menjadi kelengkapan laboratorium. Alat ini berfungsi untuk media cair dan padat (agar) siap pakai mencakup semua bidang dalam bidang farmasi… selengkapnya
Rp 800.000 Rp 900.000NB : UNTUK PENGIRIMAN WAJIB MENGGUNAKAN EKSPEDISI JNE YES Ik Media Agar Darah Blood Agar Base Alat Laboratorium Disposable 1 pack Blood Agar Base adalah Alat laboratorium yang terbuiat dari bahan plastik berfungsi sebagai wadah atau tempat untuk pertumbuhan bakteri pada sel darah. Spesifikasi : – Nama : blood agar base – 1 pack… selengkapnya
Rp 910.000 Rp 1.250.000